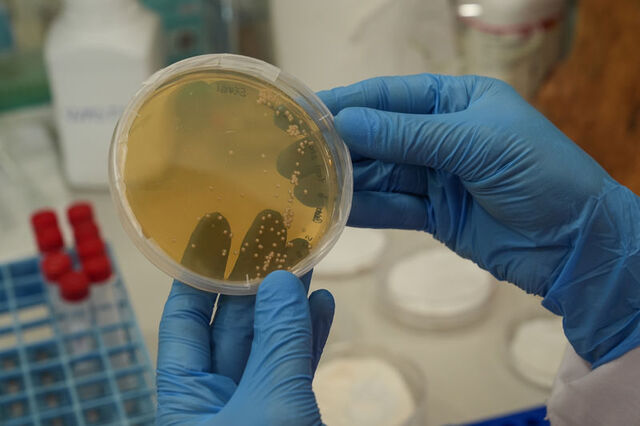

Atık pamuk saplarından katma değerli "biyomalzeme" elde edildi
İzmir Yüksek Teknoloji Enstitüsü (İYTE) ve Malezya'dan araştırmacıların ortak projesinde, atık pamuk saplarından, yara bandından yüz maskesine, akıllı telefon pilinden yapay deriye kadar birçok üründe kullanılabilecek yüksek değerli biyomalzeme elde edildi. Projenin detaylarını anlatan İYTE Fen Fakültesi Moleküler Biyoloji ve Genetik Bölümü Öğretim Üyesi Prof. Dr. Sami Doğanlar, bu malzemelerin sektörde belirleyici hale geleceğini ifade etti. Proje ekibinden yüksek lisans öğrencisi Sevgi Aslan da üretim sürecini anlattı
İzmir Yüksek Teknoloji Enstitüsü (İYTE) ve Malezya'dan araştırmacıların ortak projesinde, atık pamuk saplarından yüksek değerli biyomalzeme elde edildi.
Türkiye Bilimsel ve Teknolojik Araştırma Kurumu (TÜBİTAK) İkili İşbirliği Programları kapsamında İYTE ile Malezya Tarımsal Araştırma ve Geliştirme Enstitüsü ortaklığında 2 yıl önce sapların ekonomiye kazandırılması amacıyla başlatılan projede olumlu sonuçlara ulaşıldı.

Laboratuvarlardaki çalışmalarda atık pamuk sapları, bakterilerle işlenerek "bakteriyel nanoselüloz (BNC)" adı verilen, doğada çözünebilen yüksek katma değerli biyouyumlu malzemeye dönüştürüldü.

Elde edilen malzeme, tekstilde sentetik elyaf yerine kullanılabilirken, sağlık alanında yara örtüsü ve yapay deri yapımında değerlendirilebilecek.

Kozmetikte maske ve serum taşıyıcı jel haline getirilen biyomalzeme, gıda sektöründe kıvam artırıcı katkı maddesi olarak kullanılabilecek.

Ürün, elektronik alanında ise esnek devre altlığı ve pil bileşeni olarak denendi.

İYTE Fen Fakültesi Moleküler Biyoloji ve Genetik Bölümü Öğretim Üyesi Prof. Dr. Sami Doğanlar, Türkiye'nin zirai üretimde önemli güce sahip olduğunu, bu çerçevede tarımsal ürün atıklarının da ekonomik değere dönüştürülmesi gerektiğini söyledi.

Her yıl pamuk üretimi sonunda tonlarca sapın ortaya çıktığını anlatan Doğanlar, bunun çiftçiler tarafından yakıldığını veya toprağa gömülüp kompost (organik gübre) olarak değerlendirilmeye çalışıldığını ifade etti.

Prof. Dr. Doğanlar, bu durumun ekonomik bir kayıp olduğunu belirterek, şöyle konuştu: "Biz de bu projeyle bunları katma değeri yüksek bir ürüne dönüştürmeye çalıştık. Projemizde, son zamanlarda kullanım alanı popüler hale gelen bakteriyel nanoselülozlar üretilmesi amaçlandı. Bakteriyel selülozlar, neredeyse yüzde 100'e yakın saflıkta bir selüloz ve çok çeşitli kullanım alanları var. Dünyada da kullanımı gittikçe artıyor. Biz de tarımsal atıklarımızı değerlendirmek için bu projeyi Malezyalı bilim insanlarıyla birlikte hazırladık."

Bu malzemelerin sektörde belirleyici hale geleceğini anlatan Doğanlar, "2019'da bakteriyel selülozların dünya çapındaki ekonomik değeri 300 milyon dolar. 2026 yılında ise 1 milyar dolar olması bekleniyor. Bu her sene katlanarak artıyor. Bu, geleceğin endüstrisi" dedi.

Proje ekibinden yüksek lisans öğrencisi Sevgi Aslan da üretim sürecinde önce atıkların çeşitli analiz süreçlerinden geçirildiğini, ardından yapısal bileşenleri belirlenerek kimyasal ve enzimatik ön işlemler uygulandığını söyledi.

Bu sürecin sonunda bitki duvarındaki selülozun basit şekerlere ayrıldığını ve bakterilerle fermantasyon başlatıldığını dile getiren Aslan, şunları kaydetti: "Ortalama 10 günlük sürecin ardından besiyerinin (bakteriyi besleyen özel laboratuvar ortamı) üst tabakasında jelimsi bir BNC tabakası oluşuyor. Biz bunu topluyor, yıkıyor ve kurutarak saf, dayanıklı ve yüksek katma değerli bir biyomalzeme elde ediyoruz. Projenin bu aşamasında pamuk sapını kullanıyoruz. Malezyalılar ise meyve atıklarını yani gıda atıklarını bakteriyel selüloz üretmek için kullanıyor."
Laboratuvar sürecinin ardından elde edilen verilerin karşılıklı olarak paylaşıldığını belirten Aslan, projenin geliştirilmesi için çalışmaların süreceğini bildirdi.